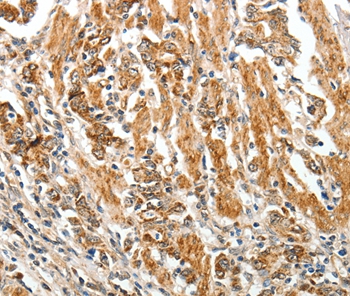

Western Blot analysis of various samples using TGF beta Receptor I Polyclonal Antibody at dilution of 1:750.
TGF beta Receptor I Polyclonal Antibody
E-AB-70130
Product group Antibodies
Overview
- SupplierElabscience
- Product NameTGF beta Receptor I Polyclonal Antibody
- Delivery Days Customer12
- CertificationResearch Use Only
- Scientific DescriptionThe protein encoded by this gene forms a heteromeric complex with type II TGF-beta receptors when bound to TGF-beta, transducing the TGF-beta signal from the cell surface to the cytoplasm. The encoded protein is a serine/threonine protein kinase. Mutations in this gene have been associated with Loeys-Dietz aortic aneurysm syndrome (LDAS). Multiple transcript variants encoding different isoforms have been found for this gene.
- UNSPSC12352203